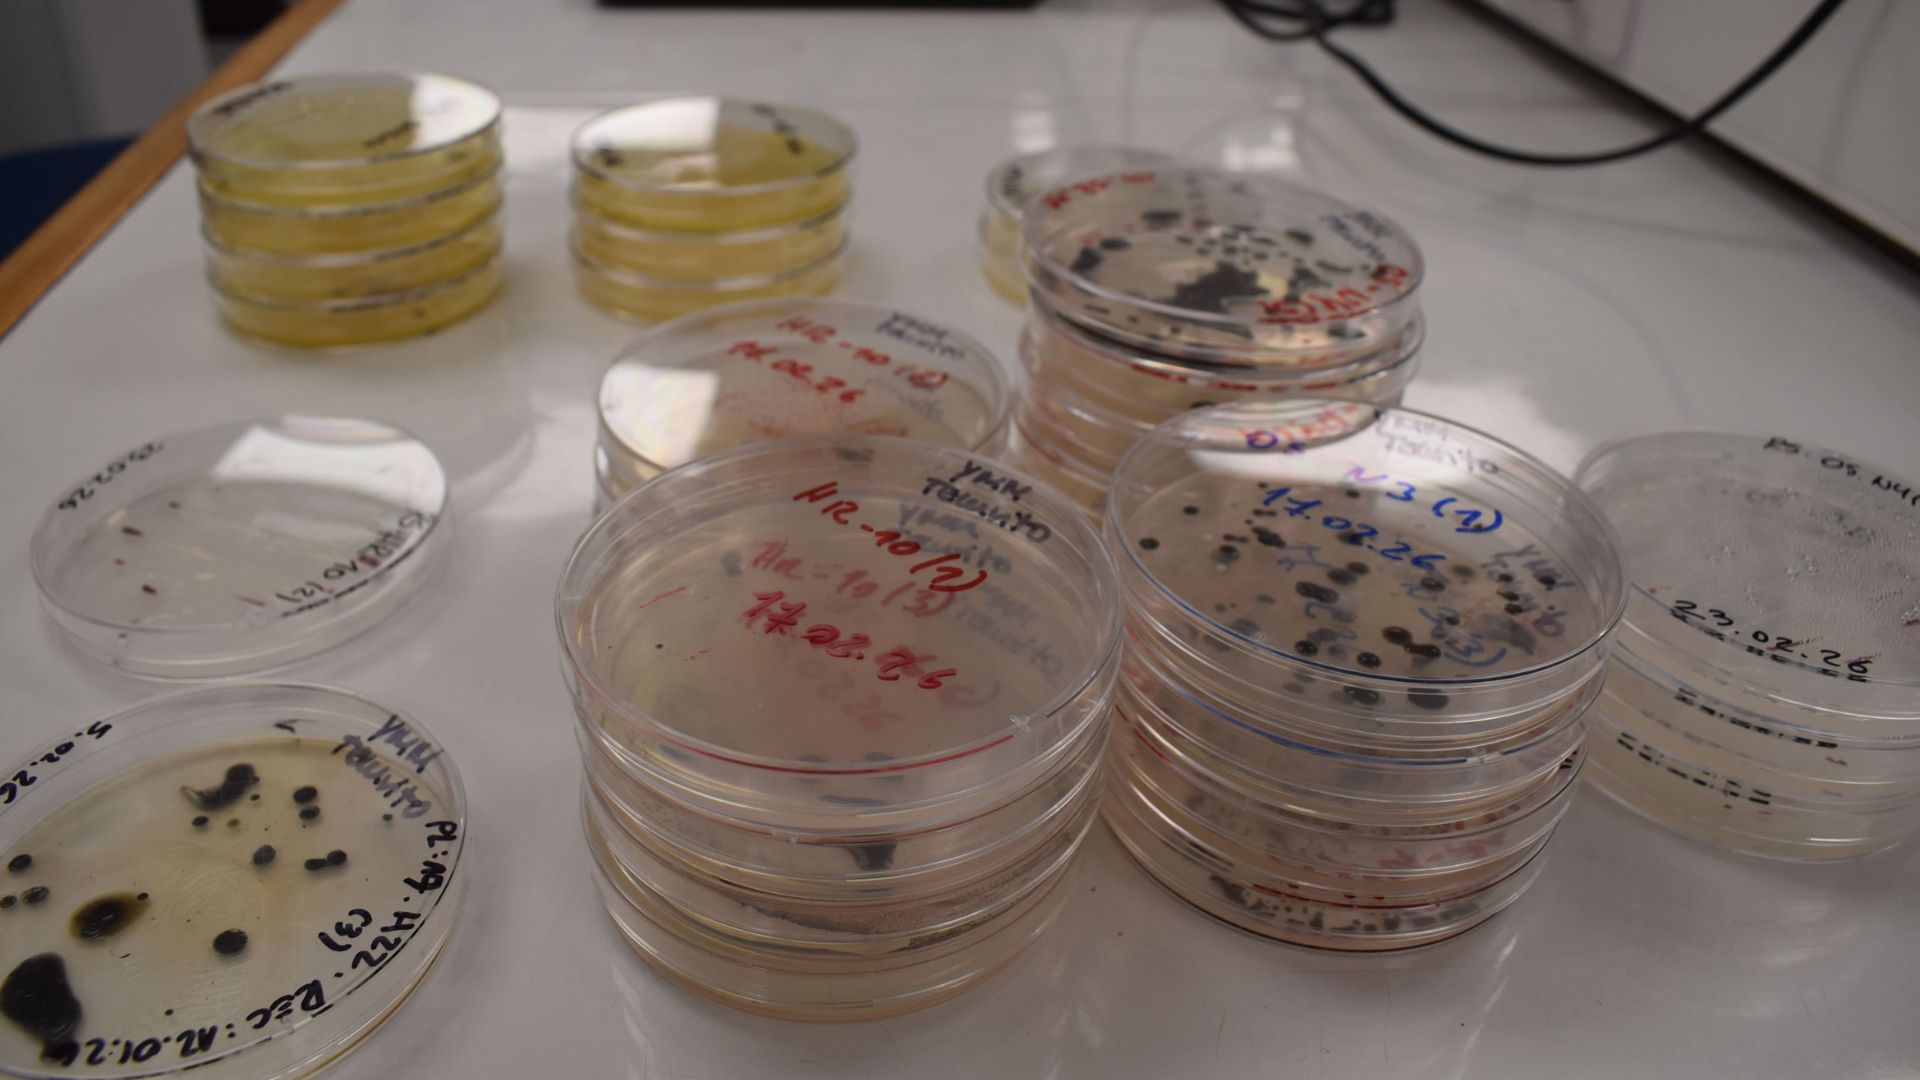
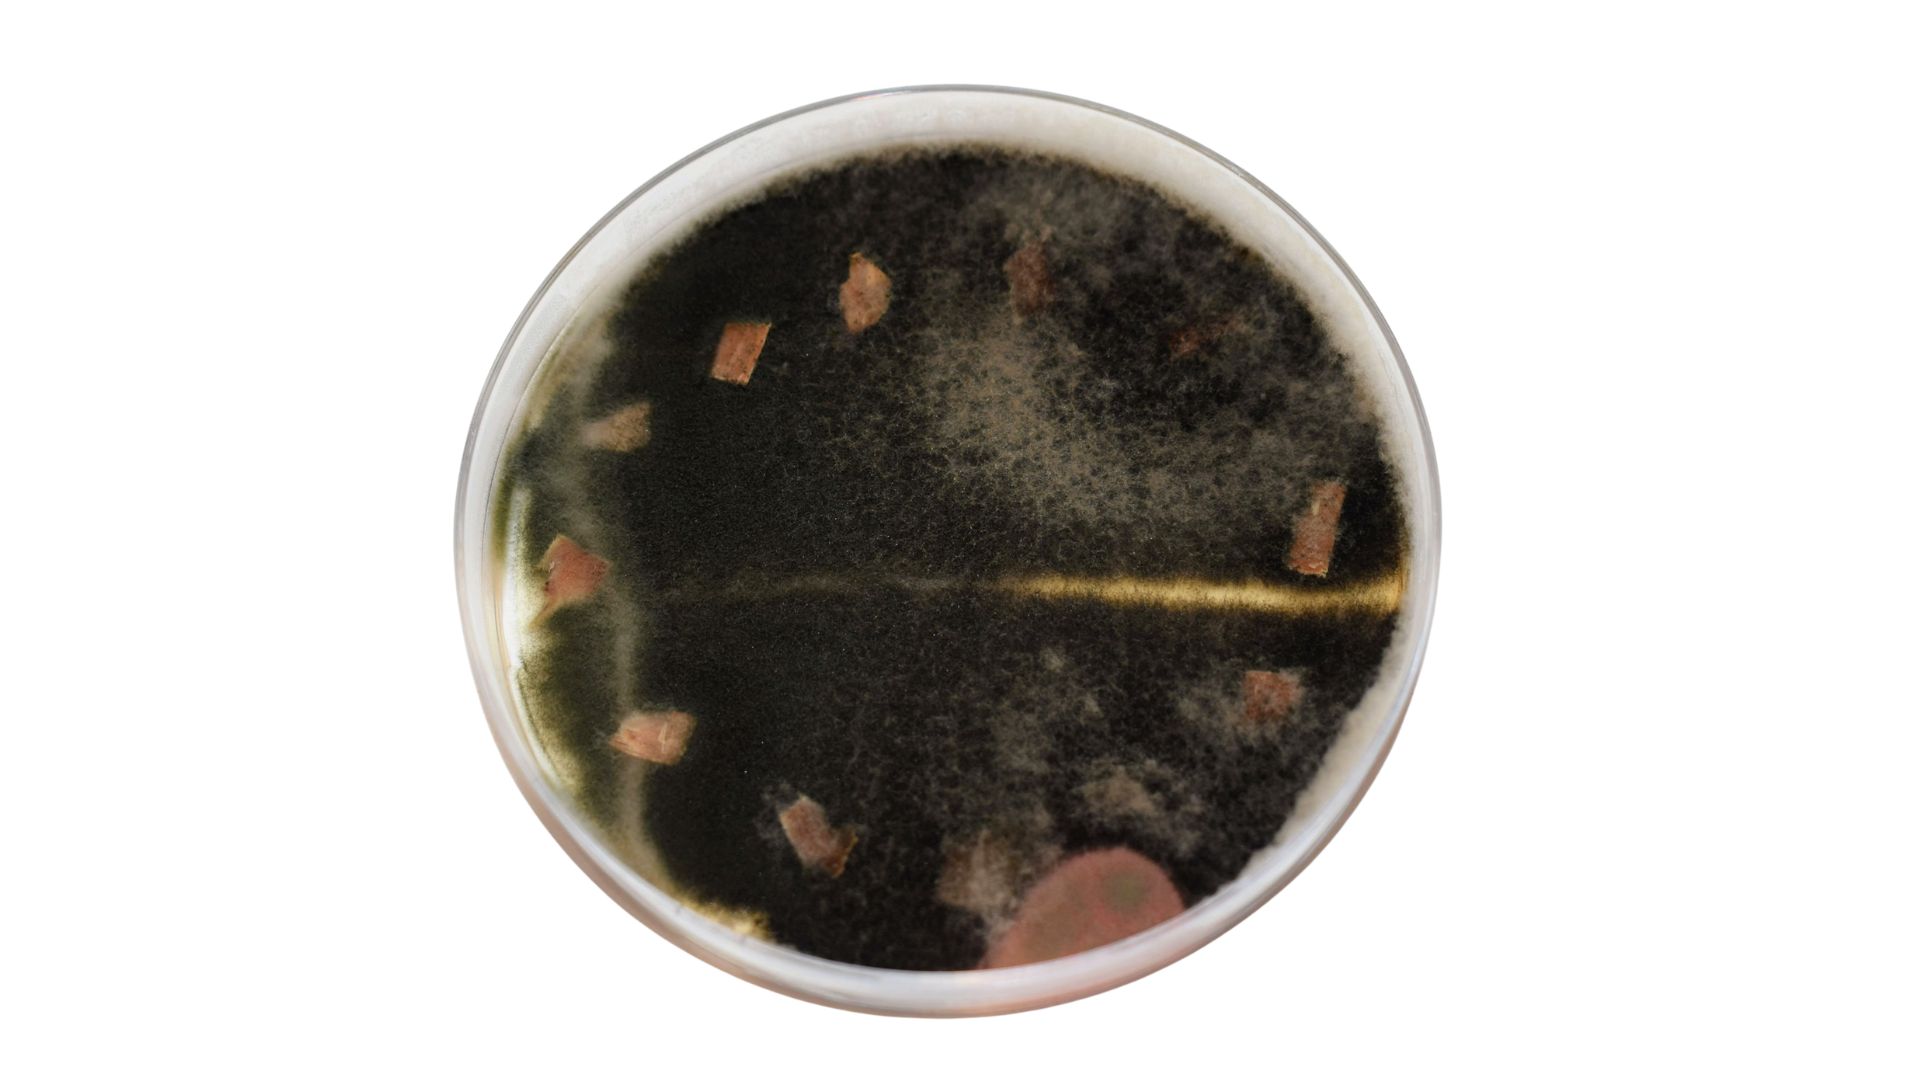
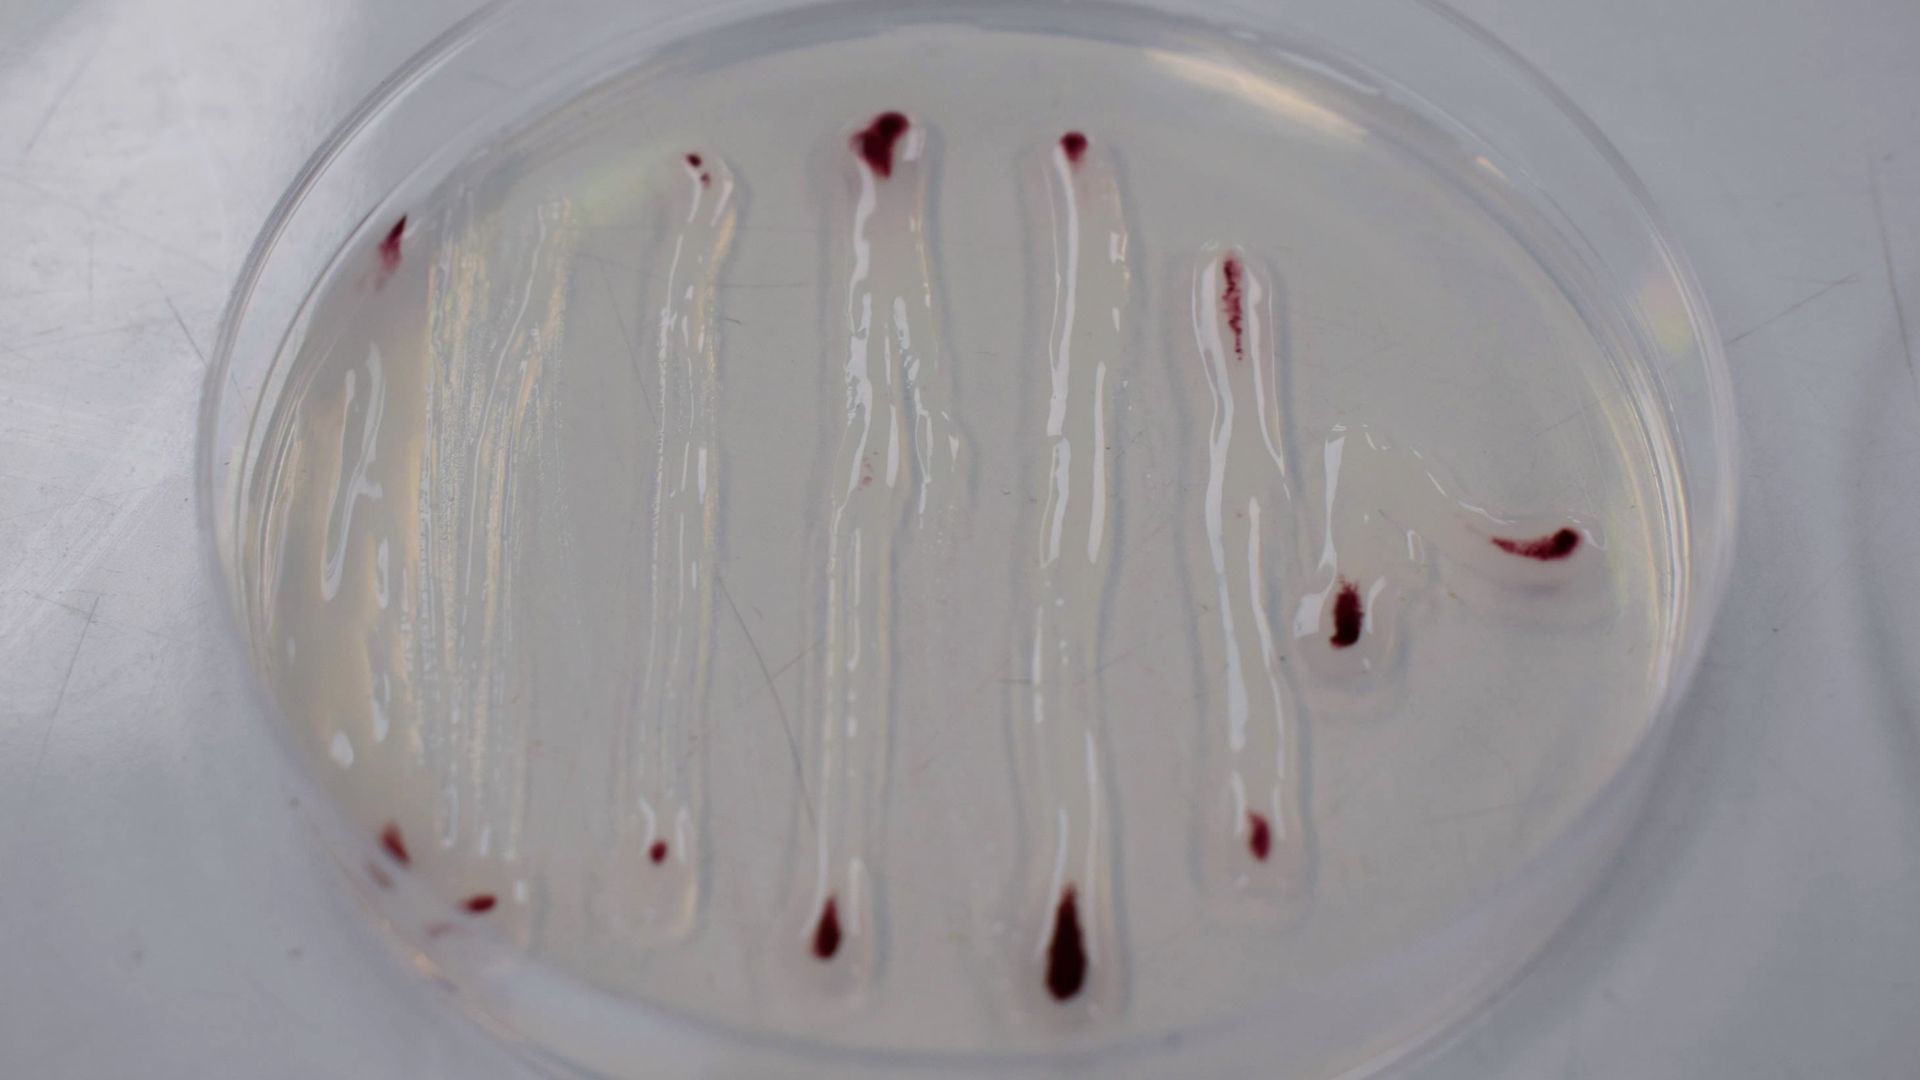

La Unidad de Fitopatología desarrolla investigación orientada al diagnóstico, epidemiología y manejo de enfermedades causadas por hongos y bacterias que afectan cultivos hortícolas y frutales.
Su trabajo integra herramientas de diagnóstico, estudios epidemiológicos y estrategias de manejo sustentable, contribuyendo a mejorar la sanidad vegetal y la resiliencia de los sistemas productivos agrícolas.
Personal Fitopatología
Personal de INIA La Platina dedicado al desarrollo e investigación del área de Fitopatología
Laboratorio de Fitopatología
Las enfermedades causadas por fitopatógenos afectan todo tipo de cultivo, carecen de control químico, se diseminan rápidamente en campo mediante vectores y pueden ser causantes de grandes impactos económicos de tipo negativo. La investigación en Fitopatología nos permite actualizar la situación virológica del país y dar un soporte a los agricultores.
Identificación y detección de enfermedades
Identificar y caracterizar las especies presentes en cultivos hortícolas y huertos frutales del país, lo que permite a su vez desarrollar estrategias de control indirectas.
Análisis
- Detección precoz de enfermedades en flores y frutos (7 a 14 d.)
- Análisis fitopatológicos de suelos y sustratos (tiempo variable).
Epidemiología
El estudio del desarrollo de enfermedades en poblaciones es de vital importancia para determinar las estrategias de control.
Análisis
- Monitoreo de packing, análisis de la calidad sanitaria de las líneas de proceso de postcosecha, cámaras y agua de lavado (7-10 días).
Saneamiento de enfermedades
Mediante esta línea de trabajo, la Unidad de Fitopatología realiza el saneamiento a los materiales de plantas madres generadas para proyectos y materiales de interés de los productores.
Análisis
- Ensayos de eficacia y validación de productos en campo.
- Evaluación in vivo e in vitro de fungicidas, bactericidas, plaguicidas biológicos y bioestimulantes.
Correo
fitopatologia.laplatina@inia.cl
Teléfono
(2) 2577 9208- 9138
Dirección
INIA La Platina, Avda. Santa Rosa 11610 La Pintana, Santiago
Proyectos
Proyectos desarrollados por INIA La Platina en el área de Fitopatología
Contacto
Si requiere información sobre los servicios del Laboratorio de Fitopatología u otros que presta INIA La Platina en esta área, contáctenos y nuestro equipo le entregará orientación especializada.